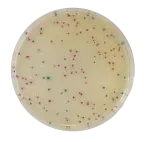
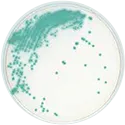
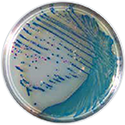
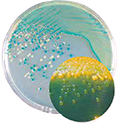
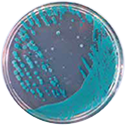

在微观世界里,每一类微生物都拥有其独特的“生物指纹”。传统的检测方法如同大海捞针,耗时长、步骤繁琐,且结果判断依赖经验,可能存在误差,而真正的挑战在于:如何快速、准确地从复杂的样本中检测出致病微生物,将风险扼杀在摇篮里?

岛津AccuDia系列显色培养基的出现,解决了以上种种痛点。其核心技术在于特异性酶底物,通过降解显色酶底物来识别目标细菌群落,仅通过观察菌落颜色,就能实现初步鉴定,大大提升了检测效率和准确性。

来看看我们的
“菌落调色盘”——微生物鉴定指南
XM-G琼脂培养基 —— 区分大肠埃希氏菌与大肠菌群 | |
生长示例: 大肠埃希氏菌:蓝色(蓝色~蓝紫色)菌落 大肠菌群:红色(粉红色~红紫色)菌落 应用: 适用于水质和食品卫生的快速评估等 | ![]() |
X-GAL琼脂培养基 ——专筛大肠菌群 | |
生长示例: 大肠菌群:蓝色(蓝色~蓝绿色)菌落 | ![]() |
X-SA琼脂培养基 —— 锁定金黄色葡萄球菌 | |
生长示例: 金黄色葡萄球菌:青(水)蓝色菌落 凝固酶阴性葡萄球菌(CNS) :白色或浅蓝色微小菌落 应用: 适用于食品行业(特别是即食食品)中金黄色葡萄球菌的快速筛查 | ![]() |
XM-sakazaki琼脂培养基 —— 专攻克罗诺杆菌 | |
生长示例: 克罗诺杆菌:蓝色~深蓝色菌落 大肠菌群:红紫色菌落 应用: 适用于婴幼儿奶粉及其生产环境样本中的克罗诺杆菌的严格检测 | ![]() |
X-VP琼脂培养基 —— 甄别副溶血性弧菌 | |
生长示例: 副溶血性弧菌:蓝色~蓝绿色菌落 创伤弧菌、霍乱弧菌、拟态弧菌:淡桃红色~红紫色菌落 溶藻弧菌:不显色,呈乳白色菌落 应用: 适用于食品行业(海鲜及海鲜制品等)中的弧菌菌属的检测 | ![]() |
X-BC琼脂培养基 —— 筛查蜡样芽孢杆菌 | |
生长示例: 蜡样芽孢杆菌:蓝色~绿色菌 应用: 适用于食品行业(米面制品、乳制品等)中的蜡样芽孢杆菌的筛查 | ![]() |
无论是近期正处于舆论漩涡的食品安全事件,还是关乎每个人健康的公共卫生挑战,快速、准确的病原体检测都是守护安全防线的基石。 岛津AccuDia系列 显色培养基,以其卓越的性能,正广泛应用于食品厂、第三方检测机构、疾控中心等领域,为保障人民生命健康贡献着岛津的力量。
立即咨询:
岛津(上海)实验器材有限公司 客户服务热线:
800-820-7730
400-920-7730